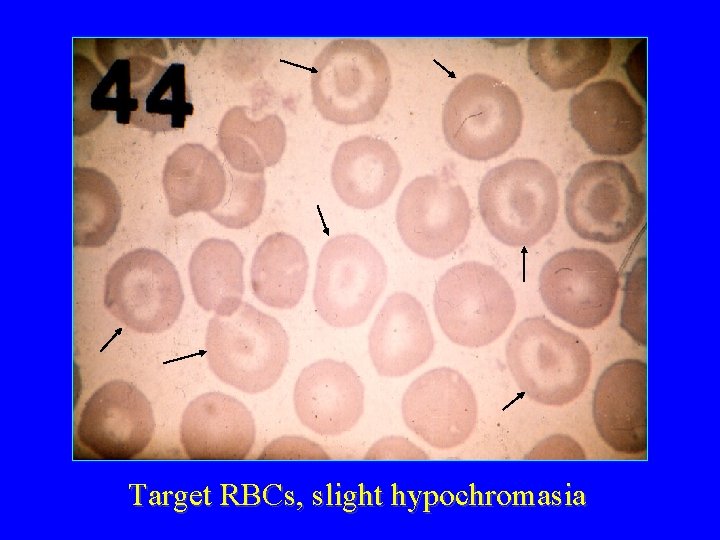
Target RBCs, slight hypochromasia

Anaemias I Iron deficiency anaemia ACD Dr Judit

- Slides: 49
Anaemias I Iron deficiency anaemia, ACD Dr. Judit Demeter Semmelweis Egyetem ÁOK. , I. sz. Belgyógyászati Klinika
History taking in patients with haematological disease 1. Non-specific symptoms fatigue, fevers, weight loss Symptoms relating to anaemia Symptoms relating to neutropenia Evidence of compromised immunity Details of haemostatic problems Anatomical symptoms reduced exercise capacity, angina, ankle oedema recurrent oral ulceration, skin infections, sepsis recurrent oropharyngeal infection easy bruising, bleeding episodes, rashes abdominal discomfort (spleen), CNS symptoms (spinal compr)
History taking in patients with haematological disease 2. Past medical history Transfusion history Drug history: prescribed and non-prescribed medications Alcohol, tobacco consumption Occupation, hobbies Travel (HIV infection, malaria) Family history: inherited haematological disorders
Normal RBC és PLT values (adult)
Normal peripheral blood smear, thin, homogenous part
Normal RBC morphology
Red blood cell maturation 1. 2. 3. 4. 5. 6. 1. : proerythroblast; 4. : oxyphil normoblast; 2. : basophil normoblast; 5. : polychromatophil RBC; 3. : polychromatophil normoblast; 6. : mature RBC
Anaemias: Kinetic approach Reduced RBC production deficiency anaemias (hematinic deficiency) (iron, B 12, folic acid) A z bone marrow disorders ( aplastic anaemia, a isolated RBC-aplasia, n e myelodsyplasia, m neoplastic infiltration) i á Increased RBC destruction (hemolysis: RBC lifespan < 100 days) s congenital hemolitic anaemias (hereditary shaerocytosis, b e sickle cell disease, t thalassaemia maior) e g acquired hemolytic anaemias (Coombs positiv hemolytic anaemia TTP-HUS) Blood loss apparent bleeding - hematemesis, melaena, metrorrhagia, epistaxis occult bleeding - slowly bleeding ulcus or carcinoma.
Examination of the anaemic patient • searching for signs of bleeding (at present or earlier) • Signs of increased RBC destruction ( hemolysis? ) • Bone marrow suppression? • Iron deficiency? Why? • Folic acid or B 12 deficiency?
Examination of the anamic patient II Medical history melaena? since what time? drug intake? (NSAID-s) geographical localisation? Physical examination severity ? tachycardia, dyspnoe, fever, hypotension hepatosplenomegaly, lymphadenopathy? (pallor) icterus? petechiae? Infections?
Anaemia in pregnancy • Dilutional anaemia: red cell mass ↑ by ~ 30% plasma volume ↑ by ~ 60% The normal Hb concentration: 10 -11 g/dl • Iron deficiency is a common problem Cause of ↑ Fe requirements ↑ Red cell mass Fetal requirements Placental requirements Basal losses over pregnancy Amount of additional Fe ~ 500 mg ~ 300 mg ~ 5 mg ~ 250 mg (1. 0 -1. 5 mg/d)
Reticulocytes in the peripheral blood smear – brillantcresilblue staining
Retikulocyte shift in anaemia With increasing severity of the anaemia and increasing erythropoetic stimulation, the reticulocytes leave BM increasingly earlier. Thus their maturation time in the periphery increases from 1 to 3 days.
Polychromatophilia in reticulocytosis A retiukulociták nagyobbak és nincs centrális halvány középük (nem bikonkávak)
Iron homeostasis The amount of iron passing from mucosal cells into the body is determined by the rate of erythropoiesis and the state of body iron stores.
-Anaemia is typically the first clue to iron deficiency, but an isolated haemoglobin measurement has both low specificity and low sensitivity. - improve sensitivity by including measures of iron-deficient erythropoiesis such as - the transferrin iron saturation, - mean corpuscular haemoglobin concentration, - erythrocyte zinc protoporphyrin, - percentage of hypochromic erythrocytes or - reticulocyte haemoglobin concentration. However, these results changes in iron def. indistinguishable from ACD. The optimal dg: serum ferritin as an index of iron stores and serum transferrin receptor as a index of tissue iron deficiency.
Testing for iron-deficiency Receiver operating characteristic (ROC) curves showing the sensitivity and specificity of various tests for the diagnosis of iron deficiency [ferritin, red cell protoporphyrin, transferrin saturation, mean red cell volume (MCV), and red cell volume distribution width (RDW)]. Note that, at any given level of sensitivity or specificity, serum ferritin outperforms all the other tests shown
Hypochromasia, anulocytes
Causes of iron deficiency Reproductive system GI tract menorrhagia Dietary oesophagitis, oesophageal varices, hiatus hernia, peptic ulcer, IBD, haemorrhoids carcinoma: stomach, colorectal coeliac disease, atrophic gastritis, gastrectomy vegans, elderly Physiological growth spurts, pregnancy Others PNH, frequent blood donation, Malabsorption hookworm
Blood loss in gastrointestinal disease ACUTE Immediately following acute haemorrhage - RBC indices usually normal ACUTE ON CHRONIC RBC indices show low normal CHRONIC or marginally ↓, film shows mixture of normochromic & hypochromic RBCs (dimorphic) RBC indices show established chronic Fe deficiency features ↓ MCV, MCH, platelets often ↑
Control of iron absorption Pathways of iron absorption and excretion in an intestinal mucosal cell. Normal iron absorption is 1 mg/day with a total daily intake of 10 mg. Iron absorption: enhanced in iron deficiency, and diminished in iron overload.
Factors influencing the absorption of dietary iron Absorption of heme iron Amount of heme iron, especially in meat Content of calcium in the meal Food preparation (time, temperature) Absorption of nonheme iron Iron status Amount of potentially available nonheme iron Balance between positive and negative factors Positive factors Ascorbic acid Meat or fish Negative factors Phytate (in bran, oats, rye fiber) Polyphenols (in tea, some vegetables and cereals) Dietary calcium Soy protein
Role of specific proteins in iron metabolism • Transferrin (Tf) • Transferrin receptor (Tf. R) • Ferritin • Iron regulatory protein 1 and 2 (IRP 1 and IRP 2), the cellular iron sensing proteins • Divalent metal transporter 1 (DMT 1, Nramp 2, DCT 1, Solute carrier family 11, member 2 (Slc 11 a 2)), the duodenal iron transporter • Ferroportin (Ireg 1, Slc 11 a 2, Mtp 1), the cellular iron exporter • Hephaestin, which likely cooperates with ferroportin for exporting iron to transferrin. • HFE, mutations responsible for the common form of hereditary hemochromatosis • TFR 2, mutations responsible for a rare form of hereditary hemochromatosis • Hemojuvelin, a hepcidin regulator, mutations responsible for the common form of juvenile hemochromatosis • Hepcidin, the key negative regulator of intestinal iron absorption + macrophage iron release. Mutations cause a rare form of juvenile hemochromatosis.
Some truths’ about ferritin — the cellular storage protein for iron - a huge protein, consisting of light and heavy chains, which can store up to 4500 atoms of iron within its spherical cavity -an acute phase reactant, and, along with transferrin and the transferrin receptor, is a member of the protein family that orchestrates cellular defense against oxidative stress and inflammation Much of the stored iron is accessible for metabolic needs. Ferritin within erythroid precursors may be of special importance in the donation of iron for heme synthesis, Ferritin measured clinically in plasma is usually apoferritin, a non-iron containing molecule. The plasma level generally reflects overall iron storage 1 ng of ferritin per m. L → 10 mg of total iron stores. A normal adult male: plasma ferritin level of 50 to 100 ng/m. L = iron stores of appr. 500 to 1000 mg A serum ferritin <10 to 15 ng/m. L is 99 percent specific for making a diagnosis of iron deficiency. An elevated serum ferritin ( in the absence of infection or inflammation) suggests the presence of an iron overload state.
Distribution of body iron in men and women 70 kg man _____ 60 kg woman ______ Iron stores - transferrin, ferritin, hemosiderin 1. 4 g 0. 3 g* Hemoglobin 2. 5 g 1. 9 g Myoglobin 0. 14 g 0. 13 g Heme enzymes 0. 01 g 0. 01 g ________________________________ TOTAL 4. 05 g 2. 34 g
Laboratory tests in iron deficiency of increasing severity Normal Fe deficiency without anemia Fe deficiency with mild anemia Severe Fe deficiency with severe anemia Marrow reticuloendothelial iron 2+ to 3+ None Saturation (SIron/TIBC), percent 20 -50 30 <15 <10 Hemoglobin, g/d. L Normal 9 to 12 6 to 7 Red cell morphology Normal Slight hypochromia Hypochromia and mikrocyt serum ferritin, ng/m. L 20 to 200 <20 <15 <10 Other tissue changes None Nail and epithelial changes
KN born: 1961 2007 Abdominal cramps, bloody stool, colonoscopy : M Crohn 2009 aug prolapsus recti Status: pallor no perimalleolar anasarca no tachycardia, but systolic murmur RDV: stool Weber: + FBC: Ht: 0, 18 Hb: 54 g/l ret: 35 % MCV: 65 fl (n: 80 -97) WBC : norm CRP: 0 Plt : 582 G/l INR norm serumiron: 3, 0 TIBC: 87, 8 serum folic acid, serum B 12 : normal soluble transferrin receptor : 27, 6 (norm: 1, 9 - 4, 4) serumferritin: 7 ng/ml (norm: 10 -120)
Normal curve Mikrocytosis Cell-Dyn 3500
Target RBCs, slight hypochromasia
Target RBCs in thalassaemia minor
Anisocytosis, microcytosis in irondeficiency
Anulocytes, hypochromasia in iron-deficiency
Anaemias – morphological approach
Change of RBC indices in the course of successful iron treatment 1999. 10. 01: vvs: 4. 16 Hgb: 72 Ht: 25 MCV: 61 1999. 10. 30: vvs: 4. 56 Hgb: 107 Ht: 34 MCV: 74 1999. 12. 10: vvs: 4. 87 Hgb: 125 Ht: 39 MCV: 79 2000. 04. 19: vvs: 4. 83 Hgb: 138 Ht: 41 MCV: 86
Causes of failure to respond to oral iron therapy Coexisting disease interfering with marrow response Infection Inflammatory disorder (eg, rheumatoid arthritis) Concomitant malignancy Coexisting folic acid and/or vitamin B 12 deficiency Bone marrow suppression from another cause Dg. incorrect, diff. diagnosis Thalassemia Lead poisoning Anemia of chronic disease (anemia of chronic inflammation) Copper deficiency (zinc toxicity) Myelodysplastic syndrome/refractory sideroblastic anemia Patient not taking the medication Medication is being taken but is not being absorbed cont’d
Cont. Medication is being taken but is not being absorbed Enteric coated product: coating is not dissolving Malabsorption of iron (eg, sprue, atrophic gastritis) Agents interfering with absorption (eg, antacids, tetracycline, tea) Continued blood loss -Cause treatable (eg, bleeding peptic ulcer) -Cause not treatable (eg, Osler Weber Rendu disease) or not by oral iron (eg, renal failure responding to Epo)
CALCULATION OF PARENTERAL IRON DOSE Body weight (kilograms) = BW 68 kg Hemoglobin concentration (g/d. L) = Hgb 5, 5 g/dl Concentration of elemental iron in the parenteral product (mg/m. L) = C* 12, 5 mg/ml Assumptions: Blood volume is 65 m. L per kilogram Hemoglobin concentration to be corrected to 14. 0 g/d. L No additional iron to be given for repletion of body stores Intermediate calculations: Blood volume (d. L) = 65 (m. L/kg) x body weight (kg) ÷ 100 (m. L/d. L) 65 x 68/100=44, 2 dl Hemoglobin deficit (g/d. L) = 14. 0 - patient hemoglobin conc. 8, 5 g/dl Hemoglobin deficit (g) = hemoglobin deficit (g/d. L) x blood volume (d. L) 8, 5 x 44, 2=375 g Iron deficit (mg) = hemoglobin deficit (g) x 3. 3 (mg Fe/g Hgb) 375 x 3. 3=1237, 5 mg Volume of parenteral iron product required (m. L) = Iron deficit (mg) ÷ C(mg/m. L) 99 ml= 20 ampulla Final calculations: Hemoglobin iron deficit (mg) = BW x (14 - Hgb) x (2. 145) Volume of product required (m. L) = BW x (14 - Hgb) x (2. 145) ÷ C
Anaemia of chronic diseases (ACD)
Anemia of chronic disease - bone marrow iron stain
Anaemia in rheumatoid disease Autoimmune phenomena warm antibody AIHA, DAT+ film show reticulocytosis Drug related problems Chronic blood loss, macrocytosis from antimetabolite immunosuppressives: azathioprine, Mtx, oxidative haemolysis to dapsone, sulfasalazine (rare AIHA due to NSAID), unforeseeable marrow aplasia 2 to other organ problems hypersplenism, Felty’s syndrom, renal failure in SLE
Determination of soluble transferrin receptor irondeficiency ACD: Anaemia of chronic disorders Combined causes Normal
Myelodysplastic syndrom- refractory anaemia with ring sideroblasts
GUIDELINES FOR RED CELL TRANSFUSIONS IN ADULT Need based on estimation of lost blood volume: Ø Need based on hemoglobin concentration: Hgb <7 g/d. L: RBC transfusion indicated. If the patient is otherwise stable, the patient should receive 2 units of packed RBC, following which the patient's clinical status and circulating Hg. B should be reassessed Hgb 7 to 10 g/d. L: Correct strategy is unclear Hgb >10 g/d. L: RBC transfusion not indicated High risk patients: Patients >65 and/or those with cardiovascular or respiratory disease may tolerate anemia poorly. Such patients may be transfused when Hgb <8 g/d. L.
reticulocyta Microcytás an. E Hemolizis Fe n/ TVK n/ ferritin Lép nem tap Krónikus betegséget kísérő anaemia Vashiányos an. Ólommérgezés